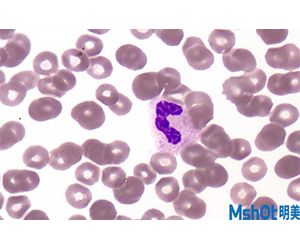

Guangzhou Micro-Shot Technology Co., Ltd
- Home
- Companies
- Guangzhou Micro-Shot Technology Co., ...
- Products
- MSHOT - Model MC50-S - 5.0MP Microscope ...

MSHOT - Model MC50-S -5.0MP Microscope camera MC50-S
Use of 5.0 megapxiels Sony CMOS sensor, MC50-S offers high performance microscope color image. Imaging performance compatible to same sensor size Sony CCD camera. The camera equipment with global shutter allows the camera accurate tract and capture dynamic images, USB3.0 interface transfer data in high-speed, the features make sure MC50-S camera focus image clearly in time. It is a high performance digital camera compatible to bright field, phase contrast, polarizing and routine fluorescence.Most popular related searches
fluorescence imaging
microscopy
material science
microscopy camera
fluorescence microscope
imaging microscopy
upright microscope
camera microscope
geology

- Sony 5MP 2/3 inch sensor
- 37.5 fps at full resolution, max 56fps
- Global shutter
- Long exposure time to 10s
- Effective gain 1X~16X
- Can offer 16bit color image
- 64Mb cache to store image data
- Support DirectShow / TWAIN
- USB3.0 port
- Clinical diagnose
- Pathology: Slides, HE, IHC, TCT, etc bright field.
- Phase contrast: Live cell, sperm, etc transparent or liquid.
- Fluorescence: FISH, static fluorescence imaging, upright fluorescence microscope imaging, etc.
- Polarizing: material science, geology, etc.
- Metallurgical
- Dark field
- Stereo
- DIC
